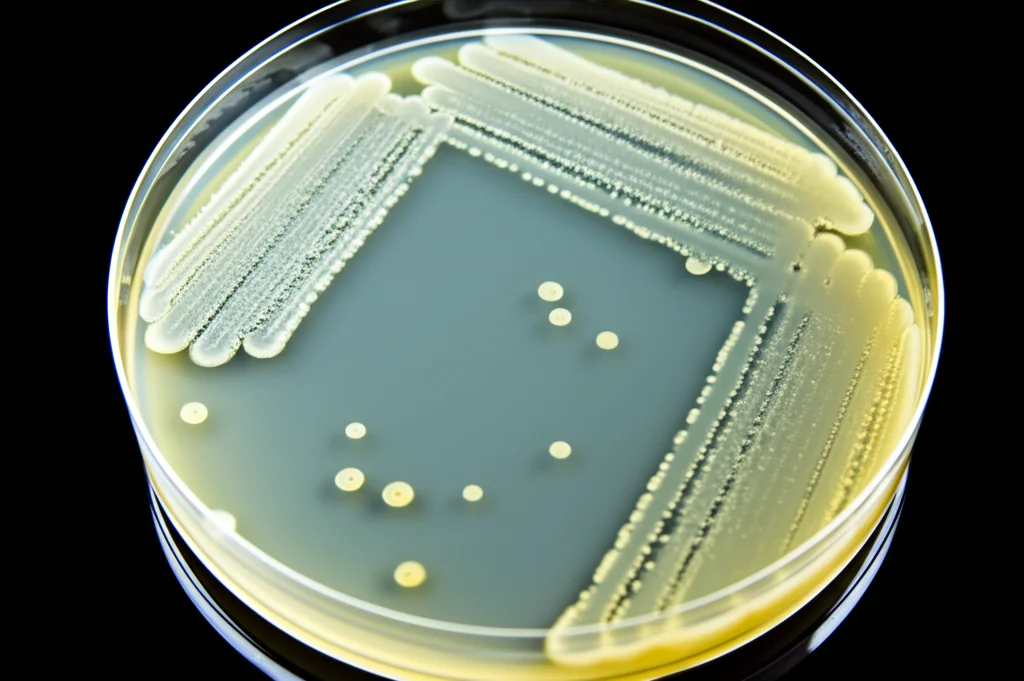
Macro fotografia, lente 60mm, alta definizione, illuminazione controllata, di una piastra Petri con colonie batteriche di E. coli che crescono su terreno agarizzato, vista dall'alto.

E. coli al Lavoro: Come Abbiamo Potenziato un Enzima Chiave per la Chimica Verde!
Ciao a tutti! Oggi voglio portarvi con me in un viaggio affascinante nel mondo della biocatalisi, un campo dove sfruttiamo la potenza della natura, in particolare degli enzimi microbici, per creare composti utili in modo sostenibile. È un po’ come avere delle minuscole fabbriche biologiche che lavorano per noi, ed è un’area della chimica verde che mi appassiona tantissimo!
Un Enzima Speciale: Il CHMO
Al centro della nostra avventura c’è un enzima chiamato Cicloesanone Monoossigenasi (CHMO). Fa parte di una famiglia super interessante, le Baeyer-Villiger monoossigenasi (BVMO), capaci di trasformare chetoni in esteri e lattoni usando semplice aria come fonte di ossigeno. Immaginate le potenzialità per sintesi più pulite ed efficienti!
Il nostro “operaio” per produrre questo enzima è un batterio molto conosciuto e robusto, l’Escherichia coli, che abbiamo geneticamente modificato (nello specifico il ceppo BL21(DE3)(pMM04)) per ospitare il gene del CHMO, originariamente isolato da un altro batterio, l’Acinetobacter sp. NCIMB 9871.
Ma non basta inserire il gene. Per ottenere un biocatalizzatore “a cellula intera” (cioè usando le cellule batteriche vive e intatte come contenitori dell’enzima) con un’attività specifica elevata, dobbiamo curare ogni dettaglio: dalle condizioni in cui facciamo crescere i batteri, alla progettazione del bioreattore, fino alle condizioni operative durante la reazione.
L’Importanza dell’Ossigeno e del Tempismo
Una delle prime cose che abbiamo indagato è stata l’importanza dell’ossigeno. Come noi, anche l’E. coli aerobico ha bisogno di ossigeno per crescere bene. Abbiamo misurato l’impatto del coefficiente volumetrico di trasferimento dell’ossigeno (un parametro tecnico chiamato kLa, che in pratica ci dice quanto efficientemente l’ossigeno passa dall’aria al brodo di coltura) sulla velocità di crescita specifica delle nostre cellule di E. coli ricombinanti.
I risultati sono stati chiari: aumentare il kLa faceva crescere i batteri più velocemente. Abbiamo trovato il punto ottimale a un kLa di 31 h⁻¹. A questo valore, la crescita non era più limitata dalla disponibilità di ossigeno. Sembrava che avessimo trovato il “respiro” giusto per i nostri piccoli operai!
Ma non è solo questione di quanto ossigeno dare, ma anche di quando chiedere alle cellule di iniziare a produrre l’enzima. Questo processo si chiama “induzione”. Abbiamo scoperto che indurre la produzione di CHMO durante la fase di crescita esponenziale (quando le cellule sono più attive e si moltiplicano rapidamente) portava all’attività specifica più alta del nostro biocatalizzatore, quando poi lo usavamo come “cellule a riposo” (cioè metabolicamente attive ma che non si dividono più). Indurre troppo tardi, quando le cellule entravano in fase stazionaria magari per mancanza di nutrienti, riduceva l’efficienza.
La Sfida dell’Induzione: Trovare la Ricetta Perfetta
Una volta capito che dovevamo indurre durante la crescita esponenziale e con un buon apporto di ossigeno (kLa = 31 h⁻¹), ci siamo concentrati sull’ottimizzazione del processo di induzione stesso. L’induttore che usiamo è una molecola chiamata isopropil-β-D-tiogalattopiranoside (IPTG), una sorta di “interruttore molecolare” che dice al batterio: “Ok, ora inizia a produrre CHMO!”.
Qui le variabili in gioco erano principalmente due:
- La concentrazione di IPTG: quanto interruttore usare? Troppo poco e la produzione non parte, troppo e potremmo stressare le cellule o ottenere enzima non funzionante.
- La durata dell’induzione: per quanto tempo lasciare acceso l’interruttore?
Abbiamo testato diverse combinazioni, facendo crescere le cellule per 5 ore (fino a raggiungere una buona concentrazione, circa 1 g/L, ancora in fase esponenziale) e poi aggiungendo IPTG a varie concentrazioni (da 0.045 mmol/L a 1.2 mmol/L) per tempi diversi (da 20 minuti a 3 ore).
La Sorpresa: Meno è Meglio!
E qui è arrivata la vera sorpresa! Contrariamente a quanto si potrebbe pensare (“più a lungo induco, più enzima ottengo”), abbiamo scoperto che un’induzione molto breve era la chiave. L’attività specifica massima del nostro CHMO l’abbiamo raggiunta con una concentrazione di IPTG relativamente bassa (0.15 mmol/L) e per una durata di soli 20 minuti!
Con queste condizioni ottimizzate, l’attività specifica del nostro biocatalizzatore a cellula intera è schizzata a 54.4 U/g (Unità di attività per grammo di cellule secche). Un miglioramento pazzesco, oltre il 130% rispetto ai valori che avevamo prima di questa ottimizzazione (circa 24 U/g)! Era quasi il doppio dell’attività riportata in studi precedenti per reazioni simili. Questo risultato è stato davvero entusiasmante, perché apriva la strada a un possibile utilizzo su scala più ampia.
Ma perché un tempo così breve? Abbiamo analizzato le proteine dentro le cellule (usando una tecnica chiamata SDS-PAGE) e sembra proprio che prolungare l’induzione oltre i 20 minuti non solo non producesse più CHMO attivo, ma potesse addirittura portare alla formazione di enzima inattivo o alla sua degradazione. Abbiamo anche provato ad aggiungere un inibitore delle proteasi (PMSF) per proteggere l’enzima, ma se da un lato sembrava ridurre la degradazione nel tempo, dall’altro rallentava anche la sua produzione. Quindi, la strategia “veloce e mirata” (5 ore di crescita, 20 minuti di induzione con 0.15 mmol/L di IPTG) si è confermata la migliore.

Mettere alla Prova il Super-Biocatalizzatore: Strategie in Bioreattore
Avere un biocatalizzatore super attivo è fantastico, ma dovevamo vedere come si comportava in condizioni più simili a quelle di un processo produttivo, cioè in un bioreattore. Abbiamo testato tre diverse strategie operative per la reazione di Baeyer-Villiger su un chetone biciclico specifico, usando le nostre cellule “a riposo” ottimizzate:
1. Aggiunte Ripetute di Substrato: Aggiungere il chetone (il materiale di partenza) a “dosi” ripetute nel tempo.
2. Alimentazione Continua di Substrato (Fed-batch): Fornire il chetone in modo continuo e graduale.
3. Uso Ripetuto delle Cellule Lavate (Batch Ripetuti): Eseguire la reazione in batch (tutto insieme all’inizio), recuperare le cellule alla fine, lavarle e riutilizzarle per un nuovo ciclo.
Le prime due strategie, sebbene permettessero di raggiungere una certa concentrazione di prodotto (lattone biciclico), hanno mostrato un grosso limite: arrivati a circa 3.3 g/L di prodotto, la reazione si bloccava completamente! Sembrava che il prodotto stesso inibisse fortemente l’attività dell’enzima CHMO, anche se le cellule rimanevano metabolicamente attive (continuavano a consumare glucosio). Aggiungere nuove cellule fresche non aiutava, confermando la forte inibizione da prodotto.
La Strategia Vincente: Lava e Ripeti!
La terza strategia, invece, si è rivelata la più promettente. Eseguendo cicli di reazione in batch, separando le cellule alla fine di ogni ciclo, lavandole e rimettendole al lavoro con nuovo substrato, siamo riusciti a mantenere l’attività del CHMO costante! Ciclo dopo ciclo, l’attività si manteneva intorno a 53 U/g, senza perdite significative. Questo approccio “lava e ripeti” sembrava superare il problema dell’inibizione da prodotto e permetteva di sfruttare al massimo la longevità del nostro biocatalizzatore ottimizzato.

Cosa Abbiamo Imparato e Prospettive Future
Questa ricerca è stata un’ottima dimostrazione di come l’ottimizzazione attenta delle condizioni di crescita e, soprattutto, di induzione possa fare un’enorme differenza nell’ottenere biocatalizzatori a cellula intera altamente performanti. Abbiamo visto che per il nostro sistema CHMO in E. coli, un’induzione breve e mirata è stata la chiave per massimizzare l’attività specifica, aumentandola di oltre il 130%.
Inoltre, testando diverse strategie operative, abbiamo identificato che l’uso ripetuto delle cellule lavate è l’approccio più efficace per mantenere alta l’attività nel tempo, superando il problema dell’inibizione da prodotto.
Questi risultati sono davvero incoraggianti! Forniscono indicazioni preziose per lo sviluppo di processi biocatalitici basati su BVMO più efficienti e sostenibili, aprendo potenzialmente la strada ad applicazioni su scala più ampia che possono beneficiare economicamente di un biocatalizzatore più attivo e duraturo. La strada della chimica verde, grazie anche a questi piccoli ma potenti operai batterici, sembra sempre più percorribile!
Fonte: Springer
